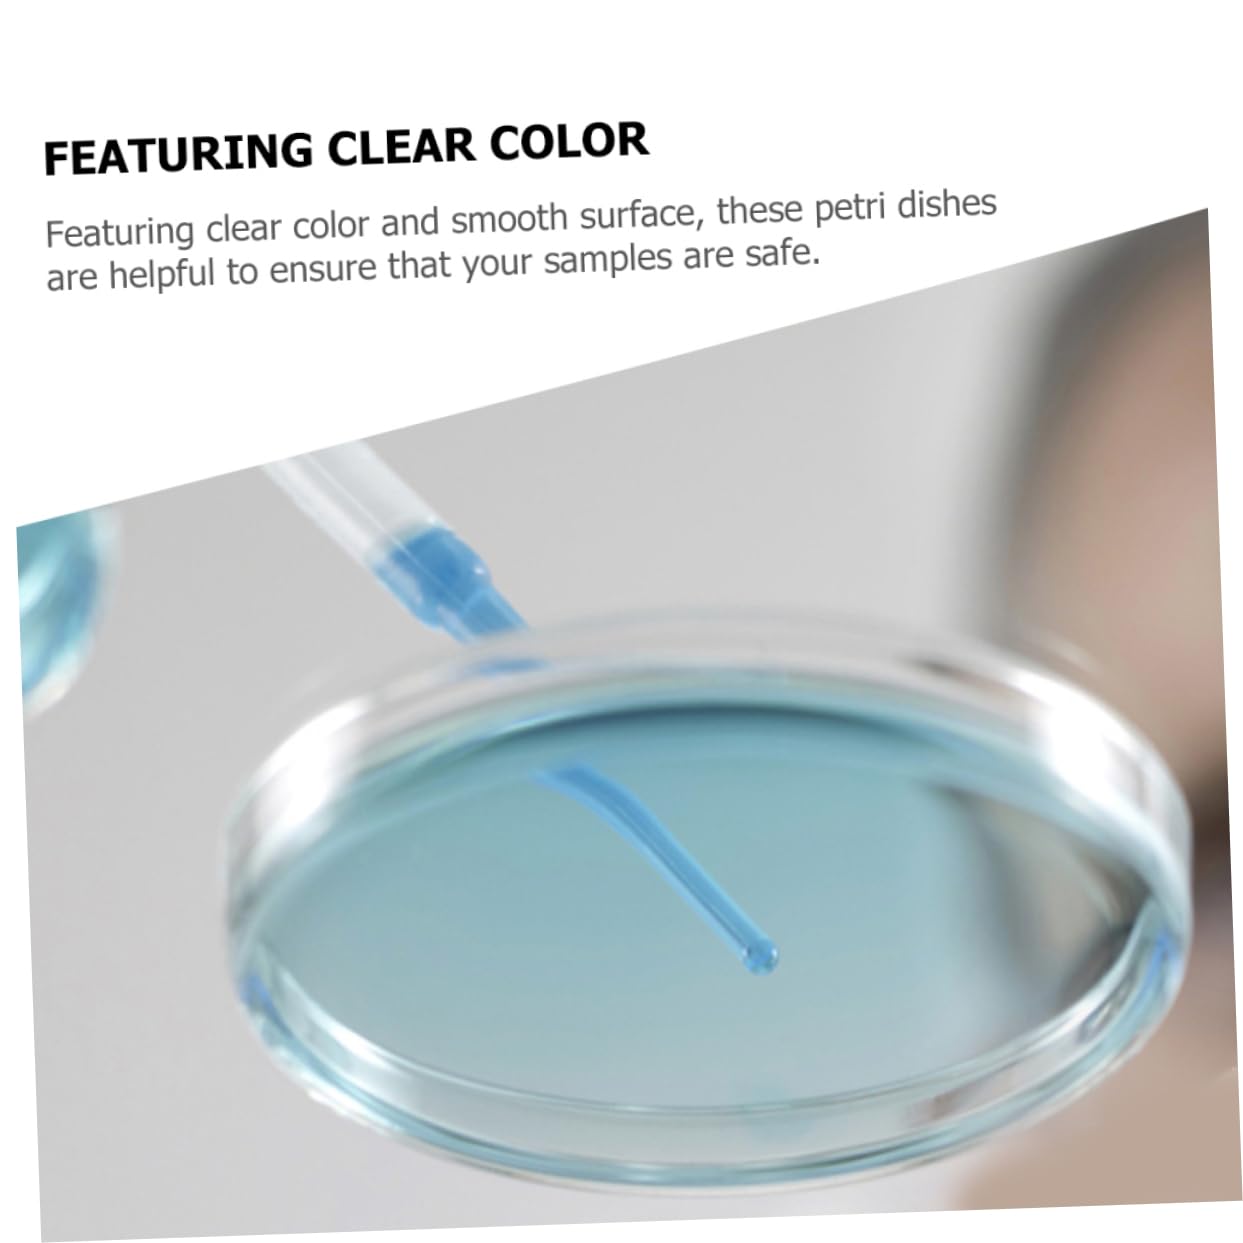
KICHOUSE 10pcs Culture Plate Petri Tray Science Experiment Supplies Plant Petri Dish Petri Dish for Experiments Petri Dishes with Lid Petri Dish Experiment Lab Tissue Culture Agar Plastic

Product Information
Specification
Brand : KICHOUSE
BulletPoint1 : Petri dish plates: this culture plate are suitable for researchers to do experiments, wonderful for cell culture use,plant seeding dish
BulletPoint2 : Petri dishes with lid: easy to observe with transparent and clear look design, and the bottom of the flat and smooth,lab
BulletPoint3 : Plate: it is made of plastic material, and sturdy for long lasting use, fine workmanship its practicality,science petri dishes
BulletPoint4 : Experiment dish: our petri dishes serve you in multiple ways and perform experiments while enhancing your learning experience,agar plates
BulletPoint5 : Blood samples dish: featuring clear color and smooth surface, these petri dishes are helpful to ensure that your samples are safe,petri dish
Color : As Shown
ItemDisplayDimensions_Length : 3.54 centimeters
ItemDisplayWeight : 0.25 pounds
ItemName : KICHOUSE 10pcs Culture Plate Petri Tray Science Experiment Supplies Plant Petri Dish Petri Dish for Experiments Petri Dishes with Lid Petri Dish Experiment Lab Tissue Culture Agar Plastic
ItemPackageDimensions_Height : 2.56 inches
ItemPackageDimensions_Length : 7.48 inches
ItemPackageDimensions_Width : 3.54 inches
ItemTypeKeyword : science-lab-petri-dishes
ItemVolume : 1 cubic_centimeters
Manufacturer : KICHOUSE
Material : plastic
ModelNumber : 7C033315NDUG9K
NumberOfItems : 1
NumberOfLithiumMetalCells : 1
PartNumber : 7C033315NDUG9K
ProductDescription : Package List
10 x Petri Dishes with Lids
Characteristics
-Material:Plastic laboratory
- Size: 9.00X9.00X1.60cm/3.54X3.54X0.63in liquid culture lids
- Color: As Shown specimen cups with lids
- Laboratory analysis for medical, , scientific research and other activities, suitable for general training plates.
- This culture plate are suitable for researchers to do experiments, wonderful for cell culture use
- You will have good use experience because of the workmanship of this product petri plates.
- Adopt excellent transparency, excellent performance, corrosion resistance and heat resistance decorations.
- Suitable for laboratory analysis, scientific research and other activities cups.
Goods Information
culture dishes with lids for science At the same time, it is more portable and can be reused, excellent and wonderful for laboratory.lab This culture plate are suitable for you to do experiments for cell culture, useful and reliable.plant seeding dish Culture plate is useful and practical for experiment use.lab dishes These cell culture dishes are made of plastic with a smooth surface that is easy to clean and reusable
ProductSiteLaunchDate : 2024-10-07T20:27:28.165Z
Size : 9.00X9.00X1.60CM
SupplierDeclaredDgHzRegulation : not_applicable
UnitCount : 1